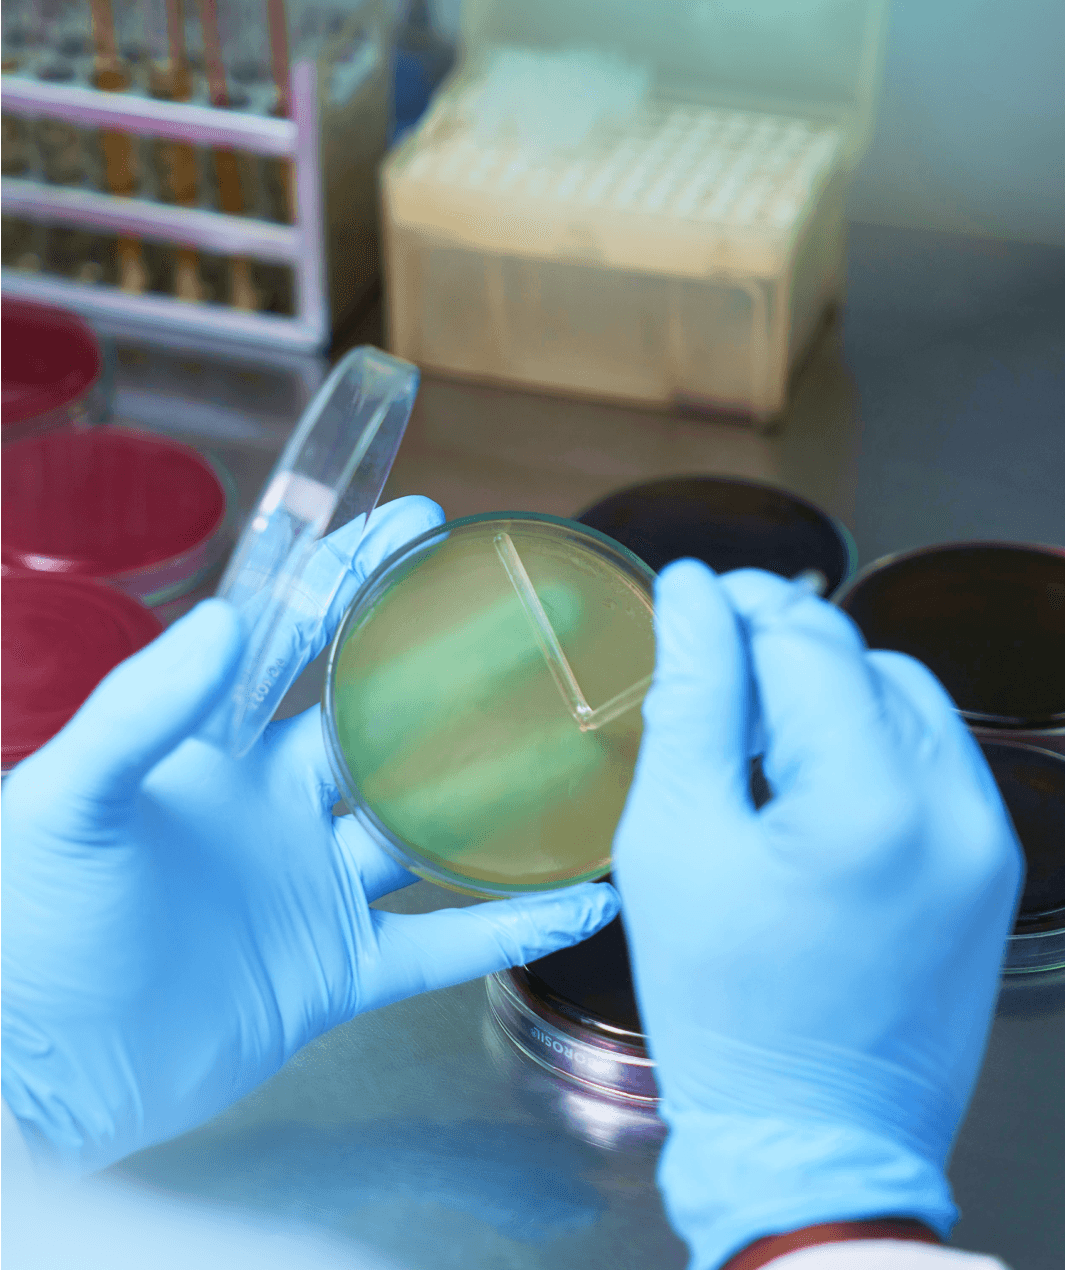
<p>Quality <i>Assurance</i></p>

Assuring Satisfaction
Through Quality
01.
Procuring Superior
Ingredients
Freshness and Quality - Our benchmarks for selecting the best ingredients.
We believe that exceptional food begins with excellent ingredients. Our raw material procurement process follows strict guidelines and utilises the most advanced technology to ensure top-notch quality.
Each item undergoes rigorous sorting and cleaning before reaching our kitchen. Customised to fit our diverse catering needs, our ingredients meet precise requirements. Freshness and quality are our key focus areas when handling each ingredient.
Procuring Superior
Ingredients

02.
Hygeine & Safety
Protecting flavours while ensuring the highest standards in food safety.
Dedicated to upholding hygiene and safety standards, we recognise that an exceptional culinary experience starts with stringent safety measures. From sourcing to serving, our commitment to food safety is unwavering and consistent.
In our food processing facilities, hygiene is non-negotiable, and we employ a multi-stage cleaning process to guarantee safety. Our team rigorously maintains sanitised spaces and adheres to industry standards at every step.
Hygeine & Safety

03.
Culinary
Craftsmanship
Experience a sky-high journey of culinary expertise with CAFS.
Our chefs, well-versed in international food safety standards, strive to make every dining experience unforgettable. At CAFS, culinary mastery defines us, merging innovation, safety, and uncompromised hygiene in every dish we prepare.
In our kitchen, every step of preparation adheres to strict safety protocols, with specialised techniques ensuring the utmost hygiene, guaranteeing that each meal meets impeccable safety standards.
Culinary
Craftsmanship

04.
Effective
Temperature control
Locking in the freshness to provide a flavourful delight in every meal.
Once our dishes are perfected, we freeze them right away to maintain their freshness. We employ sophisticated freezing techniques to ensure that the food is safe from contamination. Freezing immediately after preparation guarantees that our meals stay as safe and delicious as when they were crafted.
Temperature control ensures standards of safety and hygiene. It is about safeguarding the flavours and nutrients and, above all, ensuring that no microbes find a foothold to multiply.
Effective
Temperature control

05.
Inventory
Management
Managing inventory to ensure the best ingredient finds its rightful place.
Our prime focus is on managing inventories efficiently and effectively. Every item in our storage is placed thoughtfully, following food safety and security guidelines. We prioritise perishables and their timely use while preserving long-lasting essentials in carefully controlled environments.
Similar to our kitchen operations, where we adhere to stringent safety protocols at every step, our inventory handling also follows specialised techniques throughout the process.
Inventory
Management

06.
Quality Assurance
Preserving quality in every bite for the finest dining experience.
The quality of the ingredients used is what makes the food taste great. Each item undergoes a series of scrutiny throughout the culinary journey, ensuring only the finest and safest make their way onto our menus.
Our microbiology labs, equipped with the latest technology and expertise, scrutinise every item. With a number of quality checks, we guarantee that only the finest, safest ingredients earn their place in our kitchens.
Quality Assurance
07.
Perfection in
Preservation
Setting new standards of catering hygiene through mechanised cleaning.
We believe that maintaining impeccable hygiene is our foremost priority in delivering top-notch quality food. Through advanced technology and rigorous checks, our facilities undergo meticulous cleaning, ensuring only the safest and finest environment for food preparation.
We understand that when it comes to food preparation, cleanliness isn’t an option; it is a necessity. From automated sanitation systems to sophisticated machinery, we leave no stone unturned in guaranteeing a sterile and safe space for food preparation.
Perfection in
Preservation
